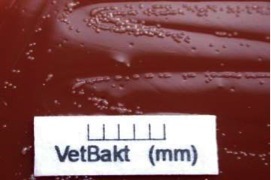
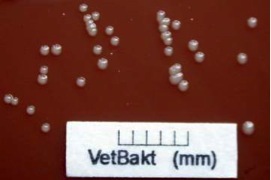

Taylorella species
Only 2 species:
Taylorella equigenitalis
Taylorella equigenitalis host
Horses
Male:
Female:
• Notifiable/ Reportable
CEM: Contagious Equine Metritis
• Immunity

Taylorella equigenitalis
CEM: Contagious Equine Metritis
Taylorella equigenitalis
Virulence factors
Taylorella equigenitalis
Environmental resistance
Taylorella equigenitalis
Epidemiology
• STD
Taylorella equigenitalis
Pathogenesis (mares)
Taylorella equigenitalis
Diagnosis in stallions
• Sampling (control)


Take sample from:
Fossa Glandis
Sinus urethralis
urethra
preputium
Taylorella equigenitalis
Diagnosis
• 2. Mares

Taylorella equigenitalis
Diagnosis
Taylorella asinigenitalis
Taylorella equigenitalis
Taylorella equigenitalis
Diagnosis
• Identification
Identification
Taylorella equigenitalis
Prevention
Elimination of positive animals from breeding
Vaccination:
Taylorella equigenitalis
Treatment